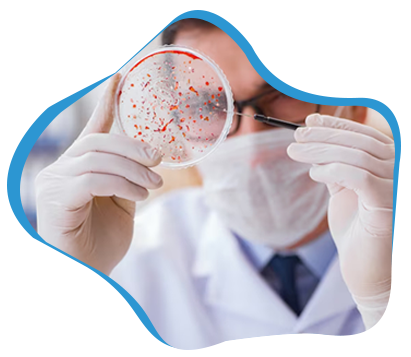

Vaginal candidiasis, or yeast infections, are a fungal infection caused by the overgrowth of Candida Albicans within the vagina. Yeast infections are one of the most common vaginal infections, affecting up to 75% of women at some point in their lives, and is more prevalent in women of childbearing age, particularly during pregnancy.
Diagnosis and treatment are crucial to resolve symptoms, prevent complications, and mitigate the possibility of recurrence. Failure to properly diagnose and treat these infections can lead to habitual infections and other health problems, such as recurrent vulvovaginal candidiasis (RVVC) (which can impact the quality of life of affected individuals). An accurate diagnosis is also important to differentiate from other infections which might present with analogous symptoms but are caused by different pathogens and require different treatment.
Causes of Vaginal Candidiasis/Yeast infection
An overabundance of the fungus Candida Albicans is the most frequent reason for vaginal yeast infections. Small amounts of this fungus Candida are naturally found in the vagina, but if it overgrows, it can cause a yeast infection.
Some of the risk factors of acquiring yeast infection includes:
- Using antibiotics which may upset the delicate balance of microorganisms in the vagina and promote the growth of Candida
- Menstruation, pregnancy, and menopause
- Conditions including diabetes that interfere with the body’s capacity to regulate blood sugar levels
- A lowered immune response
- Utilization of contraceptives with hormones and intrauterine devices (IUDs)
Several other disorders can also increase a person’s risk of getting yeast infections, such as:
- HIV/AIDS
- Therapies for cancer
- Chronic illnesses such as thyroid problems, lupus, and diabetes
- Using immunosuppressive drugs and corticosteroid medicines
- Vaginal irritation and damage, such as those brought on by radiation therapy or surgery.
Symptoms of Vaginal Candidiasis/Yeast infection
Intense itching and burning in the vagina and vulva are one of the most typical signs of a yeast infection. In addition to causing pain during urine or sex, yeast infections can make the vaginal area painful, swollen, and red. A thick, white discharge from the vagina that resembles cottage cheese is a common sign of a yeast infection. Usually odorless, the discharge occasionally emits a faint yeasty fragrance.
Yeast infections can hurt or make you uncomfortable during sex because of the soreness and inflammation in the vaginal area.
It’s important to note that some women may have asymptomatic yeast infections, which means they exhibit no symptoms at all or only very minor ones. Additionally, other illnesses including bacterial vaginosis, STIs, or an allergic reaction to vaginal products can induce symptoms that resemble those of a yeast infection (that should be ruled out by a healthcare provider through an examination and lab tests).
Treatment of Vaginal Candidiasis/Yeast infection
The most typical remedy for a yeast infection is an antifungal medicine. These may be ingested, applied topically to the affected area, or both. Butoconazole, clotrimazole, miconazole, terconazole, and fluconazole are typical antifungal drugs.
Depending on the type of antifungal drug provided and the severity of the illness, specifics will vary, but treatment typically lasts one to seven days.
Oral antifungal treatments need a prescription, but over-the-counter antifungal creams, ointments, and suppositories are accessible without one
The following self-care techniques can help alleviate symptoms and avoid recurrence in addition to medication:
- Wearing airy, loose-fitting garments
- Avoiding vaginal douches, powders, and other irritants
- Keeping up good hygiene
- Avoiding sexual activity while the infection is present
It is important to complete the full course of treatment, even if the symptoms disappear. In case of recurrent yeast infections, healthcare providers may need to consider long-term treatment or other underlying conditions.
Prevention of Vaginal Candidiasis/Yeast infection
The vaginal area should be kept clean and dry to prevent Candida overgrowth. Good hygiene habits include showering regularly and wiping from front to back after using the toilet.
Reduce the amount of moisture retained in the vaginal area and avoid Candida overgrowth by dressing comfortably in loose-fitting, breathable clothing made of natural fibers. It is not advised to dress in synthetic fabrics or tight clothing.
Managing underlying medical conditions, such as diabetes, can reduce the risk of developing a yeast infection. A balanced diet and good blood sugar control are required for this.
It is possible to reduce the transmission of yeast infections among sexual partners by using birth control techniques that act as barriers, such as condoms and diaphragms.
In Conclusion
A yeast infection is a frequent and ordinarily uncomplicated illness brought on by an overgrowth of Candida Albicans. Since the symptoms can resemble those of other vaginal illnesses, a proper diagnosis is crucial. Proper medical care and self-care can assist to reduce symptoms and stop them from returning. The likelihood of getting a yeast infection can also be decreased by taking preventative steps like practicing basic hygiene, addressing underlying illnesses, and utilizing barrier birth control.
